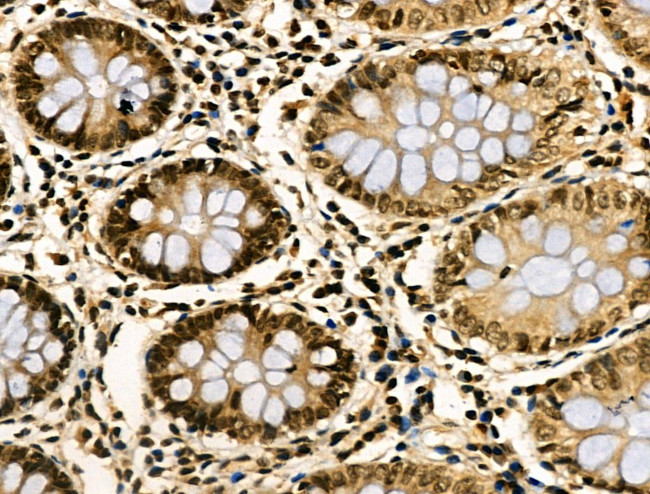
NFYA Antibody in Immunohistochemistry (Paraffin) (IHC (P))

Search
Invitrogen
NFYA Polyclonal Antibody
{{$productOrderCtrl.translations['antibody.pdp.commerceCard.promotion.promotions']}}
{{$productOrderCtrl.translations['antibody.pdp.commerceCard.promotion.viewpromo']}}
{{$productOrderCtrl.translations['antibody.pdp.commerceCard.promotion.promocode']}}: {{promo.promoCode}} {{promo.promoTitle}} {{promo.promoDescription}}. {{$productOrderCtrl.translations['antibody.pdp.commerceCard.promotion.learnmore']}}
图: 1 / 7
NFYA Antibody (PA5-118825) in IHC (P)







Please note: We are reviewing Western blot images included in the antibody testing data in our catalog, including those provided by third parties. Unless expressly labeled or annotated as “raw-unedited”, Western blot images included in the antibody testing data in our catalog may have been edited, optimized or otherwise adjusted for presentation.
产品信息
PA5-118825
种属反应
宿主/亚型
分类
类型
抗原
偶联物
形式
浓度
规格
纯化类型
保存液
内含物
保存条件
运输条件
RRID
产品详细信息
Antibody detects endogenous levels of total NFYA.
靶标信息
The NFYA gene encodes for one of the subunits of the Nuclear Factor Y (NF-Y) transcription factor, which plays a critical role in the regulation of various genes, particularly those containing the CCAAT box within their promoter regions. Structurally, NF-Y consists of a heterotrimeric complex made up of NF-YA, NF-YB, and NF-YC subunits. NF-YA serves as the sequence-specific DNA-binding component, whereas the NF-YB/NF-YC heterodimer forms a Histone Fold Domain crucial for DNA binding and stabilization. Functionally, NF-YA is pivotal in cell cycle regulation and neuronal development, influencing neural progenitor maintenance during brain morphogenesis. It has been implicated in various physiological processes, including response to plant stress and cancer progression. Specifically, NFYA gene activity is prevalent in proliferating cells and is often dysregulated in cancerous tissues, which highlights its potential as a therapeutic target. NFYA's expression in plant systems, such as in the Arabidopsis species, is modulated by environmental stresses like drought, indicating its broader impact on biological stress responses.
仅用于科研。不用于诊断过程。未经明确授权不得转售。
篇参考文献 (0)
生物信息学
蛋白别名: CAAT box DNA-binding protein subunit A; CAAT-box DNA-binding protein subunit A; CBF-A; CBF-B; CCAAT-binding transcription factor subunit A; CCAAT-binding transcription factor subunit B; FLJ11236; nf-y; NF-YA; Nuclear transcription factor Y subunit A; Nuclear transcription factor Y subunit alpha
基因别名: AA407810; CBF-A; Cbf-b; NFYA; SEZ-10; SEZ10
UniProt ID: (Mouse) P23708, (Rat) P18576
Entrez Gene ID: (Mouse) 18044, (Rat) 29508